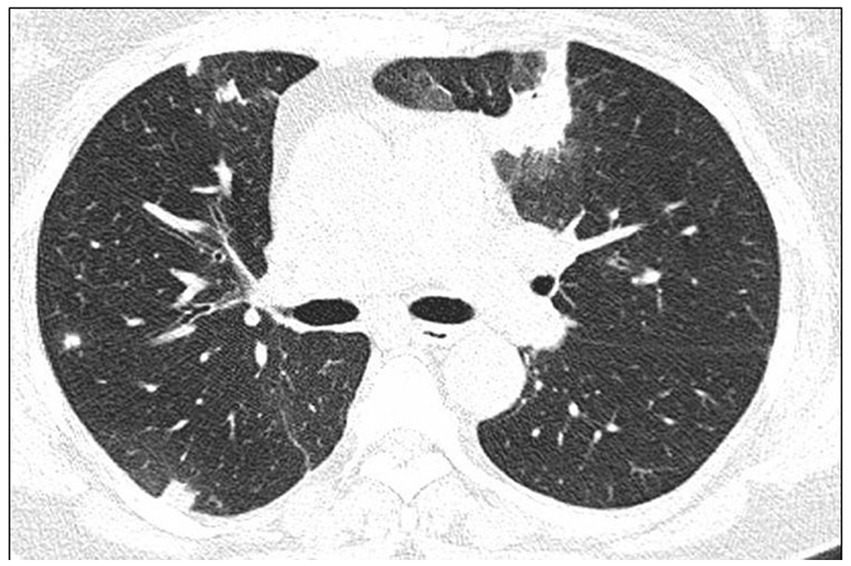
Figure 3

Abstract
Cryptogenic organizing pneumonia (COP) is a form of idiopathic interstitial pneumonia that results from the pulmonary reaction to various unidentified injuries. Secondary organizing pneumonia is diagnosed when the triggering factor has been identified; it is mainly caused by infections, toxic substance exposure, drugs, connective tissue diseases, malignancies, autoimmune diseases, bone marrow, or organ transplantation, and radiotherapy. There has been an increase in the number of reports of drug-induced organizing pneumonia (OP). New biological therapies, interferon, monoclonal antibodies, anti-interleukin antibodies, and PD1/PDL-1 inhibitors may induce this specific pulmonary reaction. The classical form of COP is usually subacute and does not manifest as severe disease. Patients maintain sufficient respiratory function, and treatment with steroids is usually effective. Several specific forms of OP (e.g., the cicatricial variant or acute fibrinous type) have distinct clinical and histological features, require higher doses of immunosuppressive drugs, and have a worse prognosis. In the era of administering steroid-sparing therapies for the treatment of interstitial lung diseases, connective tissue dases, and other conditions, it is important to emphasize this type of therapy for patients with COP.
Definition
Organizing pneumonia (OP) is a specific pulmonary reaction to a diverse range of pneumotoxic agents, both internal and external, which produce a radiologically and histologically characteristic type of inflammatory lesion that causes the distal airways to fill with an organizing fibrous exudate and inflammatory cells, in the absence of disrupted lung architecture (1–6).
According to the classification of idiopathic interstitial pneumonias proposed by the European Respiratory Society and the American Thoracic Society, OP is a separate clinical entity within this large group of diseases (1).
OP is regarded as cryptogenic organizing pneumonia (COP) when the causative factor has not been identified, and secondary organizing pneumonia (SOP) when the possible cause of disease is known (7–18) (Tables 1–3).
Table 1
| Autoimmunological diseases | Rheumatoid arthritis |
| Dermatomyositis/ myositis | |
| Sjögren’s disease | |
| Scleroderma | |
| Ankylosing spondylitis | |
| Behcét’s disease | |
| Mixed cryoglobulinemia | |
| Periarteritis nodosa | |
| Systemic lupus erythematous | |
| Chronic thyroiditis | |
| Inflammatory bowel diseases | |
| Other diseases | Acute respiratory distress syndrome (ARDS) |
| Hypersensitivity pneumonitis | |
| Chronic eosinophilic pneumonia | |
| Overlap with nonspecific interstitial pneumonia (NSIP) and usual interstitial pneumonia (UIP) | |
| Acute exacerbation of idiopathic interstitial pneumonia (with UIP pattern) | |
| Cystic fibrosis | |
| Emphysema | |
| Bronchiectasis | |
| Choking | |
| Distally from a closed bronchus | |
| As part of a reaction around an abscess or infiltrate in the granulomatosis polyangiitis (GPA) | |
| Sarcoidosis | |
| Neoplastic diseases | Tumors of the respiratory and digestive system |
| Lymphoproliferative and myeloproliferative disorders | |
| Transplantation | Bone marrow |
| Parenchymal organs including lungs | |
| Other diseases | Chronic heart or kidney failure |
| Common variable immunodeficiency and other immune disorders | |
| Coronary by-pass grafts | |
| Exposition | Toxic fumes (industrial gases, hydrogen sulfate) |
| e-cigarette or other vaping products | |
| Cocaine inhalation | |
| Marijuana smoking |
Autoimmunological diseases and other causes of SOP.
Table 2
| Viral | Human immunodeficiency virus (HIV) |
| Adenoviruses | |
| Influenza and Parainfluenza | |
| SARS- CoV-2 | |
| SARS -CoV | |
| MERS- CoV | |
| Bacterial | Mycoplasma sp. |
| Chlamydia sp. | |
| Legionella pneumophila | |
| Streptococcus pnumoniae | |
| Staphylococcus aureus | |
| Actinomyces israeli | |
| Serratia sp. | |
| Nocardia sp. | |
| Fungal | Aspergillus sp. |
| Pneumocystis jiroveci | |
| Cryptococcus neoformans | |
| Penicyllium sp. | |
| Protozoan | Plasmodium vivax |
Infectious factors which can induce SOP.
Table 3
| Antibiotics, antibacterial, and antifungal chemotherapeutics | Minocycline, |
| Nitrofurantoin | |
| Cephalosporins Amphotericin | |
| Antiarrhythmic | Amiodarone |
| Beta- blockers | |
| Phenytoin | |
| Hydralazine | |
| Timolol | |
| Biological agents | Interferons |
| Trastuzumab | |
| Rituximab | |
| Bortezomib | |
| Ceritinib | |
| Tocilizumab | |
| Etanercept | |
| Infliximab | |
| Ipilimumab | |
| Other new biological drugs | |
| Kinases inhibitors | Sirolimus, Everolimus |
| Anti EGFR inhibitors | |
| Anti ALK inhibitors | |
| PD-1/PD-L1 inhibitors | Pembrolizumab |
| Atezolizumab | |
| Nivolumab | |
| Antineoplastic chemotherapeutics | Azathioprine |
| Chlorambucil | |
| Cladribine | |
| Bleomycin | |
| Busulfan | |
| Mitomycin | |
| Methotrexate | |
| Doxorubicin | |
| Daptomycin | |
| Oxaliplatin | |
| Thalidomide | |
| Radiotherapy | Particularly breast |
| Other | Statins |
| Dihydroergocryptine | |
| Penicillamine | |
| Propylthiouracil | |
| Antiepileptics | Carbamazepine |
Drug induced SOP.
For all possible causes of OP induced by treatment see www.pneumotox.com.
The disease is classified into the following forms according to the course and nature of lesions detected during histological examination: OP, acute fibrinous organizing pneumonia (AFOP), and cicatricial variant of organizing pneumonia (CIOP) (1, 5, 6, 19–25).
Focal OP is a specific form that usually progresses asymptomatically; lesion resection is sufficient treatment in many cases (3, 5, 6).
Epidemiology
The epidemiology of OP is poorly documented. The incidence of OP differs among populations; it is estimated to be 1.97–7/100000 (3, 5, 6). An Icelandic study revealed incidences of 1.10/100000 for COP and 0.87/100000 for SOP (26). The incidence of COP has been decreasing in recent years because of improvements in the diagnosis of causative factors. Approximately 3% of patients with interstitial lung disease are presumed to have a diagnosis of OP (5, 6). According to a Greek registry, the COP prevalence is approximately 5% among patients with interstitial lung disease; a similar registry in Spain indicates that approximately 10% of patients with interstitial lung disease also have COP (26, 27). The number of patients with OP described in previous reports varies from a few cases to 48 in the study by Lazor et al., 66 patients with COP in the study by Radzikowska et al., 76 patients with COP in the study by Yoo et al., and 100 patients in the study by Yilmaz et al. (14, 28–39). Recently, Zhang et al. reported a cohort of 1,346 patients with OP, among which 176 had COP and 1,170 had SOP (40). Epler et al. evaluated 2,500 specimens from patients with interstitial lung disease; 57 (2.3%) cases exhibited bronchiolitis along with an organizing inflammatory exudate in the alveolar lumen (5).
The disease is most often diagnosed during the 5th or 6th decade of life, although cases in children have been reported. Generally, the disease exhibits no ethnicity- or sex-specific bias. Although some studies revealed that greater proportions of patients were women and nonsmokers, others indicated that OP was more common in men. At the time of diagnosis, < 30% of patients were smokers, and > 55% of patients were nonsmokers (28–40).
Etiology and pathogenesis
Damage to the alveolar basement membrane and type II pneumocytes induced by various intrinsic and extrinsic factors is an important aspect of OP development. Vascular endothelial cells are mostly undamaged. This disruption of alveolar integrity results in the leakage of a fibrotic inflammatory exudate into the alveolar lumen, which subsequently expands into alveolar ducts and respiratory bronchioles (3, 5, 6, 41–43). Polymorphic inflammatory cells and fibroblasts migrate; undergo transformation into myofibroblasts; and bind to fibronectin, collagen I, procollagen III, tenascin C, and proteoglycans within the loose extracellular matrix. The architecture of the lung parenchyma remains unchanged. Epithelial cells proliferate, causing re-epithelialization of damaged fragments. The loose extracellular matrix containing collagen III fibers is susceptible to degradation by metalloproteases, gelatinase, and stromelysin. This process also involves increased activity among inflammatory cells, which secrete multiple cytokines that stimulate the release of enzymes capable of degrading the fibrillar exudate; the cytokines also stimulate apoptotic activity in fibroblasts (44, 45). Vasculogenesis is another mechanism involved in the disease process; it is mediated by vascular growth factors, fibroblast growth factors, and matrix metalloproteinases. Although the role of alveolar macrophages is not fully understood, cytokines released by these cells (e.g., platelet-derived growth factor-β and interleukin [IL]-8) are involved in disease progression (3, 46). Elevated levels of IL-6, IL-8, transforming growth factor-β, monocyte chemoattractant protein-1, IL-10, and IL-12 are present in serum and bronchoalveolar lavage fluid (BALF) samples from patients with OP. These observations indicate that many inflammatory cells are involved in the disease process (3, 47–49). Moreover, reduced levels of IL-6 and transforming growth factor-β have been associated with response to treatment and disease resolution (47, 49). During the resolution process, the number of inflammatory cells decreases, and fibrin deposits are removed. Concentric clusters of myofibroblasts, collagen I fibers, procollagen III, and fibronectin are formed. These clusters move into the interstitium, forming collagen foci, and the alveolar surface undergoes re-epithelialization. High apoptotic activity has been observed in fibromyxoid lesions during vascularization; this process is important during lesion healing (44, 45). Disruptions during the resolution of intra-alveolar exudate and collagen foci result in the scarring variant of OP. In COP, the inflammatory process is generally simultaneous, and the lung architecture is preserved. The presence of fibrotic lesions usually suggests overlap syndromes, such as OP with nonspecific interstitial pneumonia or with usual interstitial pneumonia (3, 25, 50).
Symptoms
COP usually develops in a subacute manner, such that the first pseudo-flu-like symptoms precede diagnosis by 2–3 months. These symptoms generally include a subfebrile state, cough (often dry or with minimal sputum), decreased exercise tolerance, weakness, weight loss, chest pain, and night sweats. Rarely, patients report copious sputum; even more rarely, they report hemoptysis (< 5%) or pneumothorax. Uncharacteristic symptoms can lead to a diagnostic delay of 1–5 months (28–39).
Rarely, OP progresses to a severe form with features of respiratory failure. Its main histological counterpart is AFOP (19–24), which is characterized by richly fibrinous inflammatory exudate in the alveoli, respiratory tract, and bronchioles; this exudate comprises spherical conglomerates, observed as diffuse bilateral shadows on radiographic imaging. AFOP is most often secondary to lung transplantation, allergic alveolitis, reactions to pneumotoxic agents, connective tissue diseases, and infections. AFOP has a high mortality rate, particularly in transplant patients (3, 6, 28–40).
Patients with focal OP are usually asymptomatic.
Physical examinations reveal weakened protrusions in areas of lesions, along with the sound of fine-bubble rales. No lesions are detected during physical examinations in approximately 30% of patients (3, 5, 6, 28–39).
COP patients usually do not show clubbed fingers, but this phenomenon is evident in patients with overlap syndromes such as usual interstitial pneumonia or nonspecific interstitial pneumonia; it may also be present in patients with underlying diseases (f.c. circulatory insufficiency, neoplastic) (3, 5, 28–39).
Laboratory tests
Laboratory tests detect increases in serum C-reactive protein concentration, erythrocyte sedimentation rate, and lymphocytosis in approximately 40% of patients.
OP may precede the onset of autoimmune disease by many months or years. Thus, appropriate serological diagnostics should be conducted to assess rheumatic factor, anti-cyclic citrullinated peptide antibody, anti-nuclear antibody, anti-topoisomerase antibody (anti-SCl-70), anti-Jo-1 antibody, anti-Ro52 antibody, anti-dsDNA antibody, and other such factors (3, 5, 6, 28–39).
Radiological examination
Chest radiography
Routine chest radiography of patients with OP usually reveals bilateral opacities localized in peripheral parts of the lungs, without abnormal lung volume (Figure 1). Less frequently, diffuse lesions may be present, in the form of fine-spotted and nodules, single nodules, or mass like lesions. The changes are usually localized in the middle and lower lung fields, although they are also observed in the upper fields in one-third of patients. Lesions undergo migration in 50–75% of cases, and approximately 10% of patients exhibit spontaneous regression (3, 5, 6, 28–41, 43). The standard radiography is poorly sensitive and specific for OP.
Figure 1

Chest X-ray of OP. Bilateral opacities localized in the peripheral parts of the both lungs.
Chest computed tomography
High-resolution computed tomography (HRCT) is the gold standard in the evaluation of OP. It reveals multifocal areas of consolidation, often with a characteristic air bronchogram. Additionally, patchy alveolar consolidations, nodules, areas of ground glass opacity, perilobular infiltrations, bronchial wall thickening, and reticular fibrous changes may be present in peripheral parts of both lungs. Thickening around areas of ground glass opacity with an “atoll” or “crazy-paving” pattern may also be present, although it is less common. Additionally, nodular lesions, pleural thickening, and rarely enlargement of hilar and mediastinal lymph nodes, are present; emphysema or pleural effusion may also be observed (28–40). Honeycomb-type lesions are not in the spectrum of pulmonary changes observed in COP but might be evident in patients who exhibit interstitial pulmonary fibrosis with a component of OP (Figures 2–6).
Figure 2

High resolution computed tomography scan of a patient with COP. Bilateral ground glass opacities with associated peripheral consolidations forming an atoll sign.
Figure 3
High resolution computed tomography scan of a patient with COP. Bilateral nodular consolidations.
Figure 4

High resolution computed tomography scan of a patient with COP. Massive bilateral opacities with presence of air bronchogram and accompanying ground glass opacities on the right lung.
Figure 5

High resolution computed tomography scan of a patient with SOP in the course of dermatomyositis. In both lungs evidence of GGO with patchy distribution and parenchymal banding with “arcade” sign typical of OP. Status post lung biopsy on the right side.
Figure 6

HRCT scan. Etanercept induced AFOP, in patient with rheumatic arthritis and pulmonary fibrosis. Bilateral consolidations with air bronchogram, interlobular septa thickening, and ground glass opacities predominated in the peripheral parts of both lungs.
The micronodular form of OP is more frequently observed during the course of OP accompanying myeloproliferative diseases or infections, or after exposure to marijuana smoke (3, 28–40).
Some case series have reported higher numbers of solitary mass-like lesions mimicking lung neoplasia, whereas other case series have indicated that such lesions were present in only a few patients (Table 4) (3, 6, 40, 51, 52).
Table 4
| The most frequent | Patchy alveolar opacities |
| Consolidations with and without air bronchogram | |
| Migration of lesions | |
| Subpleural localization | |
| Bilateral lesions | |
| Frequent | Ground glass opacities |
| Reversed halo sign | |
| Nodules | |
| Multiple masses | |
| Septal thickening | |
| Rare | Lymphadenopathy |
| Reticular opacities | |
| Centrilobular nodules | |
| Perilobular and linear opacities | |
| Extremely rare | Diffuse micronodules |
| Pneumothorax | |
| Pleural effusion |
Radiological findings detected in OP patients.
Bronchoscopy and bronchoalveolar lavage
Bronchoscopy and bronchoalveolar lavage are used to exclude possible causes of the observed lesions (i.e., infections, neoplasia, eosinophilic pneumonia, and alveolar hemorrhage) (53). The lymphocyte percentage in BALF is usually high (20–40%), and eosinophils and neutrophils are present (approximately 7–10%). In approximately 40% of patients, lymphocytosis with a decreased CD4+/CD8+ lymphocyte ratio is detected, but this is not a pathognomonic finding for the disease. Patients with an increased eosinophil percentage may have overlap syndrome comprising OP with chronic eosinophilic pneumonia.
Specimens obtained via transbronchial lung biopsy may be insufficient for diagnosis, particularly when the clinical and radiological pictures are questionable. The positive and negative predictive values of transbronchial lung biopsy were approximately 94 and 40%, respectively (54). Cryobiopsy may be an effective diagnostic route (55, 56). However, the gold standard for diagnosis is histological evaluation of specimens obtained by open lung biopsy (1, 3, 5, 6, 57–59).
Histological examination
In OP, histological examination detects a rich fibrous exudate in alveolar spaces, which expands into alveolar ducts and respiratory bronchioles; it forms characteristic polypoid lesions accompanied by a polymorphic inflammatory infiltrate composed of macrophages, plasma cells, lymphocytes, and eosinophils (Figure 7).
Figure 7

Histological image of organizing pneumonia (H-E). Alveoli filled with loose tissue forming polypoid formations extending into the respiratory tracts with a small diffuse inflammatory infiltrate in the interalveolar spaces.
Some degree of inflammation is observed in the lung interstitium, but the lung architecture remains intact. The lesions usually have a unilocular appearance; typically, advanced fibrotic changes are not present at the time of diagnosis. OP involves extensive apoptotic activity in the extracellular matrix. The damaged lung is remodeled by re-epithelialization and repair of the basement membrane, along with resorption of the accompanying inflammatory exudate.
During the development of CIOP, clusters of fibrin and banded fibrous lesions are present in peribronchial spaces, sometimes accompanied by foci of dendritic ossification. This form of disease presumably results in a predisposition toward the onset of nonspecific interstitial pneumonia. Rarely, typical lesions of OP are accompanied by poorly formed granulomas (3, 5, 41).
Similarly, AFOP is detected in cases of sporadic disease with a severe and aggressive course. Histological criteria for this form are the presence of balls of organized fibrin conglomerates in the alveoli and respiratory ducts, patchy distribution in the absence of vitreous membranes, inflammatory granulomas, eosinophilic pneumonia, and bronchiolitis with abscess formation (41, 42, 57).
Pulmonary function tests
Despite the extensive radiographic changes, ventilatory parameters usually are not significantly impaired; they are within normal ranges in approximately 30% of patients. Impaired transfer rate for carbon monoxide and restrictive-type ventilatory abnormalities are most commonly detected in approximately 60–70% of patients. Features of hypoxemic respiratory failure are less frequently observed. In contrast, increased ventilatory and blood gas abnormalities are more often associated with SOP (28–38, 60).
Arterial hypoxemia at rest is uncommon (< 20% of patients), whereas arterial hypoxemia during exertion is more frequent and corresponds to impairments in diffusion capacity for carbon monoxide (3, 6, 28–40).
Diagnosis
The diagnosis of the disease is based on:
Analysis of the clinical and radiological findings
Exclusion of all possible causes of OP
Histological examination of samples obtained by open lung biopsy or transbronchial lung biopsy
Examination of lung samples obtained during transbronchial lung biopsy may be insufficient for patients with atypical clinical and radiological pictures; the OP lesions may be accompanied by other forms of interstitial pulmonary fibrosis, infections, and tumors
Diagnosis of AFOP
Rapid clinical course leading to respiratory failure
Radiological picture of extensive interstitial opacities
Histological findings of richly fibrinous inflammatory exudate within the alveoli and in the respiratory tract, along with the formation of fibrin conglomerates, while excluding the presence of vitreous membranes, eosinophilia, bronchiolitis, and granulomas
Generally, a diagnosis of COP should be based on multidisciplinary consultation (1, 3, 6).
Differentiation
Diagnosis requires a specific determination of possible etiology, particularly with respect to potentially reversible causes of disease, such as infections (e.g., coronavirus disease 2019), autoimmune disease, neoplastic disease, drug reactions, and toxic lung damage. Additionally, there is a need to determine whether OP is a component of another disease, including nonspecific interstitial pneumonia or usual interstitial pneumonia.
Chronic eosinophilic pneumonia may resemble OP in terms of clinical and radiological pictures. The disease more often affects women in the 5th to 6th decades of life, usually with a history of allergy, as well as sputum and > 25% eosinophils in BALF.
Opacities with air bronchogram are visualized by computed tomography, although they frequently do not exhibit migration; these shadows can be a sign of mucosa-associated lymphoid tissue lymphoma or adenocarcinoma of the lung.
Other forms of idiopathic interstitial pneumonitis should be considered in the differential diagnosis, and the key assessment comprises evaluation of lung sections.
Nodular lesions that raise suspicion of malignancy require histological verification. Patients who have undergone radiation therapy for breast cancer are at high risk, such that 1–3% subsequently develop OP (3, 6, 59, 61–65).
Treatment
Treatment strategies for COP should be based on assessment of the patient’s clinical status and the disease severity, with particular attention to respiratory sufficiency. The disease spontaneously resolves in <10% of cases.
Patients with localized COP treated by surgical resection of the lesion have a good prognosis; this is frequently sufficient treatment (40).
Steroid administration is the standard treatment for COP and SOP. Clinical and radiological improvements occur within a few days after the initiation of treatment; however, approximately 50% of patients experience recurrence, including approximately 20% who have multiple recurrences of COP. Relapses mainly occur during the first year after the initial episode. New infiltration occurs during steroid tapering (< 10 mg of prednisone) or within a few months after the completion of treatment. The factors associated with greater probability of relapse have not been fully elucidated, and different case series have yielded discordant results. However, putative factors include diagnostic and treatment delays, respiratory insufficiency, extension of pulmonary infiltrates, the presence of multifocal opacities, higher levels of inflammatory markers, and the presence of gastroesophageal reflux. Recurrence does not affect the mortality rate, and prolonged steroid treatment does not prevent recurrence. However, prolonged steroid treatment increases the likelihood of adverse events during therapy, which occur in 12–50% of patients; some events can be very severe, including pulmonary embolism, vertebral fracture, diabetes, and tuberculosis. The possibility of secondary causes of disease (e.g., autoimmune diseases and malignancy) should be considered in patients with recurrent OP. The optimal steroid dosage regimen and duration of therapy have not been established. The most common recommendation comprises the administration of 0.5–1 mg/kg per day of prednisone in gradually decreasing doses for 6–12 months. The dose and duration of treatment should be modified in accordance with the patient’s clinical condition. Relapses are usually treated with lower doses of steroids (approximately 20 mg/day for 6 months) (28–40) (Table 5).
Table 5
| Authors | Patients no | Initial dose of PRE | Duration of treatment (months) | Complete response rate n (%) | Rapid progression | Relapse n (%) | Adverse events | Observation period (months) |
|---|---|---|---|---|---|---|---|---|
| Epler et al. (5) | 37 | NR | 3–12 | 24 (65%) 9 (%) partial response | 8 from 24 (33%) | 2 deaths from OP 2 pulmonary embolism 1 death aneurysm | Mean 4 years, range 2–10 years | |
| King (6) | 96 | NR GR:1–1.5 mg/kg/d | NR GR: About 12 | 76 (63%) | NR 30 (37%) persistent disease | 11 (12%) patients died | NR | |
| Lohr et al. (62) | 20 | 51 mg/d | Mean 12.7 | 4(13%) | 5-year survival 73% | 36–48 | ||
| Cazzato et al. (33) | 43 | 40 mg/d (20-120 mg/d) | 6–9 | NR 5 spontaneous remissions | 2 | 15 (26%) | 3 deaths | NR |
| Lazor et al. (28) | 48 | 50 ± 17 mg/d | >12 68% patients were still on treatment | 20 (42%) | 28 (58%) | 12(25%) No deaths | 35 ± 31 23 median | |
| Barroso et al. (63) | 33 | 56 ± 12 mg/d | Non relapsed 12 ± 3; Relapsed 42 ± 10, p < 0.01, multiple relapsed 98 ± 48 months, p = 0.03 | 14/32 (44%) | 18/32 (56%) | 2 patients died (one of tuberculosis) | 33 patients alive at 144 months 2 patients were on steroids in the time of analysis | |
| Yoo et al. (14) | 76 36- PRE 40- PRE+ CTX | 54.6 ± 12.6 mg/d | 10.5 (4.0–14.7) | 35 (46%) | Rapid progression 5 (6.6%) Stabile 2 (2.6%) | 14 (20%) | 11 (14.5%) Disease related death | Median 38.2 (13.0–68.6) |
| Sveinsson et al. (64) | 40 | 42.4 mg/d | NR | NR | 8 (20%) | NR | Mean 4.7 years | |
| Drakopanagiotakis et al. (38) | 30 | NR | Nr | 17 (47%) | 13 (43%) | 2 (5.3%) 1-year mortality | NR | |
| Onishi et al. (39) | 40 | 0.5–0.8 mg/kg/d | 1–6 | 25 (62%) | 15 (38%) | No deaths caused by OP NR | NR | |
| Radzikowska et al. (29) | 22 (respiratory sufficient) | 0.67 ± 0.24 mg/kg/d | mean of 8.59 ± 3.05 | 21 (100%) | 12 (54.5) | 8 (6.5%) patients (1 death) | 67 ± 45.6 | |
| Saito et al. (66) | 33 | 11 severe patients received 1.0 methylprednisolone iv. for 3 days | Meantime 282 ± 183 days in non-relapse group and 281 ± 174 days in relapse group | 23 (70%) | 10 (30%) | NR | NR | |
| Zhou et al. (37) | 73 | 20-200 mg/d | 6–12 months | 60 (68.5%) | 23 (31.5%) | 50.3 ± 26.8 months (range 9.3–96.4 months) | ||
| Zhang et al. (40) | 53 | 1–2 mg/kg/d | Min. 12 | 12 (23%) | PR7 (13%) | 35 (70%) | 3 deaths | 98.3% 5-year survival |
| Radzikowska unpublished data | 32 | 0.73 ± 0.24 mg/kg/d | Mean 8.68 ± 4.08 | 32 (100%) | 17 (53%) multiple relapse 15(%) | 17 (53%) 2 deaths | 64.3 ± 46.0 No one on steroids in the time of analysis |
COP treatment with corticosteroids – observational retrospective studies of cohorts over than 20 patients (COP patients were extracted from presented populations).
CTX, cyclophosphamide; GR, general recommendations; NR, not reported; PRE, prednisone; PR, partial response.
Clinically severe forms of the disease, which mainly occur in patients with SOP, have been treated with intravenous boluses of corticosteroids (500–1,000 mg methylprednisolone intravenously for 3–5 days with subsequent oral prednisone treatment at 1 mg/kg) and other immunosuppressive drugs (e.g., cyclophosphamide, azathioprine, cyclosporine A, mycophenolate mofetil, and rituximab), usually in combination with glucocorticoids (3, 6, 24, 38–40).
Generally, COP exhibits a very good response to corticosteroid treatment in patients with respiratory sufficiency, good clinical status, and no symptoms of severe disease; steroid-sparing therapies with macrolides have demonstrated promising results. There is increasing evidence regarding the efficacy of clarithromycin (CAM) treatment in COP patients without features of respiratory distress (67–75) (Table 6). The most effective dosage regimen is oral administration of CAM at 2 × 500 mg/day for 3 months. Significant improvement occurs after 1 month of treatment, rather than within a few days (e.g., the duration expected during steroid treatment). More than 80% of patients achieve complete regression of lesions after a 3-month period of treatment, and the recurrence rate is <10%. Adverse effects of this treatment are limited to allergic reactions and dyspeptic symptoms (68). Lower doses of CAM (2 × 500 mg for 1 week, 500 mg for 3 weeks, and 250 mg for 8 weeks) in combination with prednisone also led to good therapeutic effects (63% complete regression and 38% partial regression), but 80% of the patients exhibited OP recurrence. In the control group treated for 6 months with prednisone alone, the proportions of patients who achieved complete and partial remission were 81 and 14%, respectively; relapses occurred in more than half of the patients (75).
Table 6
| Author | Patients no | Treatment | Dose of CAM | Initial dose of PRE | Duration of treatment (months) | Complete response rate n (%) | Partial response > 50% n (%) | Relapse n (%) | Adverse events |
|---|---|---|---|---|---|---|---|---|---|
| Ichikawa et al. (67) | 6 | Erythromycin 600 mg/d | 3–4 | 6 (100%) | NR Observation mean 3.8 months | without | |||
| Epler et al. (5) | 37 | PRE | 1 mg/kg/d | NR | 24 (65%) | 13 (26%) | 33% treated with PRE | 2 deaths of OP | |
| 7 | Tetracycline. erythromycin | NR | NR | 3(43%) | NR | NR | |||
| 4 | No treatment | 2 (50%) | |||||||
| Stover et al. (69) | 6 (3 COP 3 ROP) | CAM | 2×250 2×500 | 1.5–6 | 5 (83%) | 1 (17%) | 1 (17%) patient with ROP * | NR | |
| Sveinsson et al. (64) | 40 | PRE | NR | Mean 42.4 | NR | NR | NR | 22 (55%) | 1 death steroid responsive 1 death acute OP |
| 1 | Erythromycin | NR | 0 | ||||||
| 17 | Surgery | 0 | |||||||
| Drakopanagiotakis et al. (38) | 30 | PRE | NR | NR | NR | NR | 38 | 9.4% | |
| 3 | Macrolides | NR | NR | ||||||
| 9 | No treatment | ||||||||
| Pathak et al. (71) | 3 cases second line treatment 1 case first line | CAM | Two patients 2×0,5 Two patients 2×0.25 | NR | 5 or NER | 4 (100%) | NR | NR | |
| Radzikowska et al. (29) | 40 | CAM | 2 ×0.5 | 3 | 35 (88%) | 4 (10%) | 10 | 1 (2.5%) | |
| 22 | PRE | Mean 0.67 ± 0.24 mg/kg/d | 8.59 ± 3.05 | 22 (100%) | 0 | 54 | 8 (36%) 1(5%) death | ||
| Petitpierre et al. (75) | 16 | CAM + PRE | 2×0.5 for 1 week 0.5 for 3 weeks 0.25 for 8 weeks | 0.75 | 3 | 10 (63%) | 6 (38%) | 81 | 0 |
| 21 Previously published | PRE | 0.75 | 6 | 17 (81%) | 3 (14%) | 52 | 0 | ||
| Ciftci et al. (74) | 7 | CAM | 2×0.5 | 3–9 | 7 (100%) | 0 | |||
| Zhou et al. (37) | 73 | PRE | 0.75 | 12 | NR | NR | 32 | NR | |
| 8 | CAM | NR | 4.2 ± 2.7 | 7 (64%) | NR | 36 | NR | ||
| 3 | Azithromycin | NR |
COP treatment with clarithromycin – observational retrospective studies.
CAM, clarithromycin; PRE, prednisone; COP, cryptogenic organizing pneumonia; SOP, secondary organizing pneumonia: ROP, radiotherapy induced organizing pneumonia; NR, not reported, NER -not exactly reported patient with large cell lymphoma.
CAM was effective treatment for patients with radiotherapy-induced OP.
Similar to the first-line treatment, steroids are used as treatment for relapses. However, relapses can be treated with lower doses of glucocorticoids (< 20 mg/day) or CAM (5, 68).
Prophylactic treatment of Pneumocystis jiroveci infection is recommended for patients receiving steroids.
There have been no randomized controlled trials of steroid or CAM treatments for COP. The recommendations for treatment are based on individual experience and the results of uncontrolled studies. Considering the treatment duration, results, adverse events, and probability of relapse, CAM should be the first choice for treatment in patients with COP who exhibit respiratory sufficiency. Steroids should be considered for patients with a severe and aggressive disease course, particularly patients with underlying conditions (e.g., connective tissue disease, malignancy, or suspected drug reaction). Among patients who fail to respond to steroids, more aggressive treatment with cyclophosphamide, azathioprine, or rituximab is recommended.
Monitoring
Relapses of OP are common, particularly in steroid-treated patients; they most frequently occur during the period of prednisone dose reduction to approximately 5–10 mg or within 2–3 months after the completion of treatment. Therefore, follow-up examinations are recommended during the first year after completion of treatment. Additionally, particular attention is necessary for patients whose lesions have not completely resolved, and for patients in whom OP is regarded as the first symptom of a developing connective tissue disease. Factors associated with a higher risk of recurrence are diagnostic delay (> 2 months), severe disease, the presence of multifocal lesions and dilatation with stretching on radiographs, transfer factor of the lung for carbon monoxide <50%, hypoxemia <70 mmHg, and the presence of fibrin conglomerates and cicatricial lesions on histological examination (3, 28–40, 66, 68, 75).
Prognosis
Typical COP has a good prognosis. Spontaneous regression occurs in approximately 10% of cases, and > 75% of patients recover fully.
Poor response to treatment occurs in patients with a disease pattern that is suggestive of OP overlap with nonspecific interstitial pneumonia, patients in whom the disease is caused by exposure to pneumotoxic agents, patients with connective tissue diseases (including diseases induced by biological drugs), patients with myeloproliferative diseases, and patients who underwent lung or bone marrow transplantation. Very rarely, COP can result in death (3, 6, 28–40, 68–75).
Prevention
Because the cause of disease is not fully understood, there are no established methods for prevention.
Avoidance of infection is recommended; this includes efforts to undergo immunization against influenza, pneumonia, and coronavirus disease 2019.
Variants of organizing pneumonia
AFOP
More than 150 patients with AFOP have been described thus far, and the significance of the histological findings remains unclear (24, 76–80). This disease may be idiopathic or (more frequently) secondary, related to diffuse alveolar damage, adverse drug reaction, transplantation, and connective tissue disease. Although AFOP was first identified in patients with acute respiratory failure, the course of the disease can be acute or subacute. Confluent, bilateral, massive consolidations in basal areas of the lungs are usually observed. Patients with a fulminant clinical course and rapid progression to death exhibit radiological findings similar to diffuse alveolar damage, along with diffuse consolidations and ground glass opacities in lower parts of the lungs. In patients with a subacute clinical course, the radiological picture is more compatible with typical OP, including diffuse and focal consolidations with an air bronchogram and ground glass opacities. These patients also have better prognoses. Histologically, AFOP is characterized by the presence of organized fibrinous balls filling the alveoli, combined with type II pneumocyte hyperplasia and the absence of hyaline membrane. In the original report by Beasley et al., 17 patients with AFOP were identified among 114 cases with diffuse alveolar damage and OP (19). Relevant possible causes of the lesions were present in 11 patients; the possible cause of disease was unknown in the remaining 6 patients. The prognosis of AFOP is poor; 50% of the patients in the cohort presented by Beasley et al. died, including all patients who received mechanical ventilation. Onishi et al. identified 19 cases of idiopathic AFOP in a group of 34 patients diagnosed with AFOP. Corticosteroids were effective in 94% of the patients in the AFOP group, but relapses occurred in 76% of the patients (23). Additionally, a higher corticosteroid dose was needed during recurrence than during the initial course of disease. These patients had favorable outcomes, but two deaths from respiratory failure occurred among patients with underlying diseases. In that study, AFOP was more common than previously reported, and the patient prognosis was better than in other studies. In a review of cases and cohorts of patients with AFOP, Chen et al. reported that 33% of patients had idiopathic AFOP; underlying conditions responsible for disease were identified in the remaining patients (i.e., those patients had secondary AFOP) (24). Dyspnea (72%), nonproductive cough (71%), and fever (43%) were the most common symptoms, and they usually exhibited subacute onset (41%). Acute disease onset was identified in 27% of patients; it was nonspecific in the remaining patients. Bilateral consolidations, mainly in the lower and peripheral parts of both lungs, were present in 77% of patients. Consolidations, ground glass opacities, and nodules were evident in 54, 42, and 20% of patients, respectively. Lesions in the form of consolidations were more common in patients with idiopathic AFOP than in patients with secondary AFOP (70% vs. 47%, respectively). Rarely, pleural fluid (5%) and solitary nodules (1.3%) were detected in patients with secondary AFOP. Steroid administration was the most frequently prescribed therapy (88%); the dose and duration considerably varied. Immunosuppressive agents (e.g., cyclophosphamide, mycophenolate mofetil, tacrolimus, and azathioprine) were administered to 17 patients, most of whom exhibited secondary AFOP during the course of autoimmune disease. Drug-induced AFOP was identified in 17 (11%) patients; withdrawal of the possible causative drug and administration of corticosteroids were recommended (3, 6, 12).
Disease-related deaths were reported in 20% of idiopathic AFOP patients and 49% of secondary AFOP patients (80).
Moreover, close monitoring of patients with cryptogenic AFOP is recommended because it can reveal connective tissue disease or malignancy as the cause of the lesions.
Cicatricial variant of organizing pneumonia
CIOP is a rare histological variant of OP, which has been referred to by various names, including fibrosing OP, collagenized OP, and scarring variant of OP; these names should be consolidated to a single term (16, 25, 81–83). Yousem et al. found this variant in histological specimens from 12 of 223 patients with OP, which had been collected over a 20-year period. Additionally, 30 other patients had CIOP secondary to connective tissue diseases and malignancies. In this group, the disease was mainly present in middle-aged men; bilateral nodular or reticulonodular lesions were the most frequent manifestation. Histological examination revealed that fibromyxoid material filled distant airways and alveoli; dense eosinophilic fibrosis was evident in the center of the lesions, along with preservation of the lung architecture. In the central parts of these changes, elastic tissue was revealed by specific stains (e.g., Elastica van Gieson). Mild lymphocytic bronchiolitis and patchy alveolar septal infiltrates were present. In some cases, dendriform ossifications, fibrous pleuritis, and dust deposits were present. The lesions were persistent or progressive in >50% of patients. There has been discussion of separating this variant from classical COP (25). Woge et al. reported the presence of OP in 56 cases diagnosed via surgical biopsy specimens that had been collected over a period of 9 years. Thirty-two of 56 cases (57.1%) exhibited ≥10% cicatricial elements within fibromyxoid balls; cicatricial elements comprised ≥50% of OP in 9 of these cases. Intraluminal ossification was present in five of these nine cases. In 6 of these patients with major cicatricial changes, the clinical condition was good over a median follow-up period of 47 months (83).
Recently, Zaizen et al. analyzed the histological findings of 121 patients with fibrotic interstitial pneumonia; they found that CIOP coexisted with usual interstitial pneumonia, nonspecific interstitial pneumonia, and chronic hypersensitivity pneumonia patterns. CIOP as a predominant type of lesion was present in 7 of 48 patients who exhibited any CIOP changes. CIOP was regarded as a variant of OP, as well as a histological lesion that can occur within other types of fibrotic interstitial pneumonia. Moreover, the presence of CIOP in patients with fibrotic interstitial pneumonia was associated with a low risk of acute exacerbation, slight improvement of ventilatory impairment, and better prognosis (82).
Conclusion
Cryptogenic organizing pneumonia (COP) is a result on the pulmonary reaction to various unidentified injuries. It has usually subacute course, and rarely manifests as severe disease.
The diagnosis of COP requires detailed evaluation of possible causes of secondary disease such as: infections, toxic substance exposure, drugs, connective tissue diseases, malignancies, autoimmune diseases, bone marrow or organ transplantation, and radiotherapy.
There have been no randomized controlled trials of steroid, clarithromycin, and other immunosuppressive treatments for COP. The recommendations for treatment are based on individual experience and the results of uncontrolled studies. Considering the treatment duration, results, adverse events, and probability of relapse, CAM should be the first choice for treatment in patients with COP who exhibit respiratory sufficiency. Steroids should be considered for patients with a severe and aggressive disease course, particularly patients with underlying conditions (e.g., connective tissue disease, malignancy, or suspected drug reaction). Among patients who fail to respond to steroids, more aggressive treatment with cyclophosphamide, azathioprine, or rituximab should be considered.
Publisher’s note
All claims expressed in this article are solely those of the authors and do not necessarily represent those of their affiliated organizations, or those of the publisher, the editors and the reviewers. Any product that may be evaluated in this article, or claim that may be made by its manufacturer, is not guaranteed or endorsed by the publisher.
Statements
Author contributions
RE and FJ equally contributed to the conception and design of the work and drafted the article. All authors contributed to the article and approved the submitted version.
Conflict of interest
The authors declare that the research was conducted in the absence of any commercial or financial relationships that could be construed as a potential conflict of interest.
- AFOP
acute fibrinous organizing pneumonia
- CAM
clarithromycin
- CEP
chronic eosinophilic pneumonia
- CIOP
cicatricial variant of organizing pneumonia
- COP
cryptogenic organizing pneumonia
- CT
computed tomography
- HRCT
high resolution computed tomography
- NSIP
non-specific interstitial pneumonia
- OP
organizing pneumonia
- PD1
programmed death receptor 1
- PD-L1
programmed cell death-ligand 1
- PRE
prednisone
- ROP
radiotherapy induced organizing pneumonia
- SOP
secondary organizing pneumonia
- UIP
usual interstitial pneumonia
Abbreviations
References
1.
Travis WD Costabel U Hansell DM King TE Lynch DA Nicholson AG et al . An official American Thoracic Society/European Respiratory Society statement: update of the international multidisciplinary classification of the idiopathic interstitial pneumonias. Am J Respir Crit Care Med. (2013) 188:733–8. doi: 10.1164/rccm.201308-1483ST
2.
Epler GR . Bronchiolitis obliterans organizing pneumonia: definition and clinical features. Chest. (1992) 102:2S–26S. doi: 10.1378/chest.102.1.2S
3.
Cordier JF . Cryptogenic organising pneumonia. Eur Respir J. (2006) 28:422–6. doi: 10.1183/09031936.06.00013505
4.
Davison AG Heard BE McAllister WA Turner-Warwick ME . Cryptogenic organizing pneumonitis. Q J Med. (1983) 52:382–4. PMID:
5.
Epler GR Colby TV McLoud TC Carrington CB Gaensler EA . Bronchiolitis obliterans organizing pneumonia. N Engl J Med. (1985) 312:152–8. doi: 10.1056/NEJM198501173120304
6.
King TE Lee JS . Cryptogenic organizing pneumonia. NEJM. (2022) 386:1058–69. doi: 10.1056/NEJMra2116777
7.
Geddes DM Corrin B Brewerton DA Davies RJ Turner-Warwick M . Progressive airway obliteration in adults and its association with rheumatoid disease. Q J Med. (1977) 46:427–4. PMID:
8.
Cordier JF Loire R Brune J . Idiopathic bronchiolitis obliterans organizing pneumonia. Definition of characteristic clinical profiles in a series of 16 patients. Chest. (1989) 96:999–04. doi: 10.1378/chest.96.5.999
9.
Henriet AC Diot E Marchand-Adam S de Muret A Favelle O Crestani B et al . Organising pneumonia can be the inaugural manifestation in connective tissue diseases, including Sjogren’s syndrome. Eur Respir Rev. (2010) 19:161–3. doi: 10.1183/09059180.00002410
10.
Epler GR Kelly EM . Post-breast cancer radiotherapy bronchiolitis Obliterans organizing pneumonia. Respir Care. (2020) 65:686–2. doi: 10.4187/respcare.07150
11.
Radzikowska E Nowicka U Wiatr E Jakubowska L Langfort R Chabowski M et al . Organising pneumonia and lung cancer - case report and review of the literature. Pneumonol Alergol Pol. (2007) 75:394–7. PMID:
12.
Radzikowska E Szczepulska E Chabowski M Bestry I . Organising pneumonia caused by trastuzumab (Herceptin) therapy for breast cancer. Eur Respir J. (2003) 21:552–5. doi: 10.1183/09031936.03.00035502
13.
Lebargy F Picard D Hagenburg J Toubas O Perotin JM Sandu S et al . Micronodular pattern of organizing pneumonia: case report and systematic literature review. Medicine (Baltimore). (2017) 96:e5788. doi: 10.1097/MD.0000000000005788
14.
Yoo JW Song JW Jang SJ Lee CK Kim MY Lee HK et al . Comparison between cryptogenic organizing pneumonia and connective tissue disease-related organizing pneumonia. Rheumatology (Oxford). (2011) 50:932–8. doi: 10.1093/rheumatology/keq410
15.
Crestani B Valeyre D Roden S Wallaert B Dalpin JC Cordier JF . Bronchiolitis obliterans organizing pneumonia syndrome primed by radiation therapy to the breast. The Groupe dEtudes ET de Recherche sur les maladies Orphelines Pulmonaries (GERM"O"P). Am J Respir Dis. (1998) 158:1929–35. doi: 10.1164/ajrccm.158.6.9711036
16.
Ishiwata T Ebata T Iwasawa S Matsushima J Ota S Nakatani Y et al . Nivolumab-induced acute Fibrinous and organizing pneumonia (AFOP). Intern Med. (2017) 56:2311–5. doi: 10.2169/internalmedicine.8271-16
17.
López Pardo P Sánchez Peña AM Río Ramírez MT . Cryptogenic organizing pneumonia by alectinib. Med Clin (Barc). (2021) 157:91–2. doi: 10.1016/j.medcli.2020.04.058
18.
Tzortzi A Kapetanstrataki M Evangelopoulou V . Beghrakis P.a systematic literature review of E-cigarette-related illness and injury: not just for the Respirologist. Int J Environ Res Public Health. (2020) 17:2248. doi: 10.3390/ijerph17072248
19.
Beasley MB Franks TJ Galvin JR Gochuico B Travis WD . Acute fibrinous and organizing pneumonia: a histological pattern of lung injury and possible variant of diffuse alveolar damage. Arch Pathol Lab Med. (2002) 126:1064–70. doi: 10.5858/2002-126-1064-AFAOP
20.
Kim MC Kim YW Kwon BS Kim J Lee YJ Cho YJ et al . Clinical features and long-term prognosis of acute fibrinous and organizing pneumonia histologically confirmed by surgical lung biopsy. BMC Pulm Med. (2022) 22:56. doi: 10.1186/s12890-022-01852-z
21.
Cohen AJ King TE Downey GP . Rapidly progressive bronchiolitis obliterans with organizing pneumonia. Am J Respir Crit Care Med. (1994) 149:1670–5. doi: 10.1164/ajrccm.149.6.8004328
22.
Beardsley B Rassl D . Fibrosing organising pneumonia. J Clin Pathol. (2013) 66:875–1. doi: 10.1136/jclinpath-2012-201342
23.
Onishi Y Kawamura T Higashino T Mimura R Tsukamoto H Sasaki S . Clinical features of acute fibrinous and organizing pneumonia: an early histologic pattern of various acute inflammatory lung diseases. PLoS One. (2021) 16:e0249300. doi: 10.1371/journal.pone.0249300
24.
Chen H Kuang Y Huang X Ye Z Liu Y Xie C et al . Acute fibrinous and organizing pneumonia: two case reports and literature review. Diagn Pathol. (2021) 16:90. doi: 10.1186/s13000-021-01155-7
25.
Yousem SA . Cicatricial variant of cryptogenic organizing pneumonia. Human. (2017) 64:76–82. doi: 10.1016/j.humpath.2017.03.018
26.
Gudmundsson G Sveinsson O Jonsson IHJ Frodadottir H Aspelund T . Epidemiology of organising pneumonia in Iceland. Thorax. (2006) 61:805–8. doi: 10.1136/thx.2006.059469
27.
Karakatsani A Papakosta D Rapti A Antoniou KM Dimadi M Markopoulou A et al . Hellenic interstitial lung diseases group. Epidemiology of interstitial lung diseases in Greece. Respir Med. (2009) 103:1122–9. doi: 10.1016/j.rmed.2009.03.001
28.
Lazor R Vandevenne A Pelletier A Leclerc P Court-Fortune I Cordier JF . Characteristics of relapses in a series of 48 patients. The Groupe d’Etudes et de Recherche sur les Maladles ‘Orphelines’ Pulmonaires (GERM‘O’P). Am J Respir Crit Care Med. (2000) 162:571–7. doi: 10.1164/ajrccm.162.2.9909015
29.
Radzikowska E Wiatr E Langfort R Bestry I Skoczylas A Szczepulska-Wojcik E et al . Cryptogenic organizing pneumonia – results of treatment with clarithromycin versus corticosteroids – observational study. PLoS One. (2017) 12:e0184739. doi: 10.1371/journal.pone.0184739
30.
Izumi T Kitaichi M Nishimura K Nagai S . Bronchiolitis obliterans organizing pneumonia. Chest. (1992) 102:715–9. doi: 10.1378/chest.102.3.715
31.
King TE Jr Mortenson RL . Cryptogenic organizing pneumonitis. North Am Exp Chest. (1992) 102:8S–13S. PMID:
32.
Alasaly K Muller N Ostrow DN . Cryptogenic organizing pneumonia. A report of 25 cases and a review of the literature. Medicine (Baltimore). (1995) 74:201–1. doi: 10.1097/00005792-199507000-00004
33.
Cazzato S Zompatori M Baruzzi G Schiattone ML Burzi M Rossi A et al . Bronchiolitis obliterans-organizing pneumonia: an Italian experience. Respir Med. (2000) 94:702–8. doi: 10.1053/rmed.2000.0805
34.
Oymak FS Demirbaş HM Mavili E Akgun H Gulmez I Demir R et al . Bronchiolitis obliterans organizing pneumonia. Respiration. (2005) 72:254–2. doi: 10.1159/000085366
35.
Chang J Han J Kim DW Lee I Lee KY Jung S et al . Bronchiolitis obliterans organizing pneumonia: clinicopathologic review of a series of 45 Korean patients including rapidly progressive form. J Korean Med Sci. (2002) 17:179–6. doi: 10.3346/jkms.2002.17.2.179
36.
Yılmaz S Akıncı Özyürek B Erdoğan Y Cirit Koçer B Demirağ F Dadalı Y et al . Retrospective evaluation of patients with organizing pneumonia: is cryptogenic organizing pneumonia different from secondary organizing pneumonia?Tuberk Toraks. (2017) 65:1–8. doi: 10.5578/tt.53938
37.
Zhou Y Wang L Huang M Ding J Jiang H Zhou K et al . A long-term retrospective study of patients with biopsy-proven cryptogenic organizing pneumonia. Chron Respir Dis. (2019) 16:147997311985382. doi: 10.1177/1479973119853829
38.
Drakopanagiotakis F Paschalaki K Abu-Hijleh M Aswad B Karagianidis N Kastanakis E et al . Cryptogenic and secondary organizing pneumonia. Chest. (2011) 139:893–13. doi: 10.1378/chest.10-0883
39.
Onishi Y Kawamura T Nakahara Y Kagami R Sasaki S Takahashi S et al . Factors associated with the relapse of cryptogenic and secondary organizing pneumonia. Respir Investig. (2017) 55:10–5. doi: 10.1016/j.resinv.2016.09.001
40.
Zhang Y Li N Li Q Zhou Y Zhang F Chen T et al . Analysis of the clinical characteristics of 176 patients with pathologically confirmed cryptogenic organizing pneumonia. Ann Transl Med. (2020) 8:763. doi: 10.21037/atm-20-4490
41.
Colby TV . Pathologic aspects of bronchiolitis obliterans organizing pneumonia. Chest. (1992) 102:38S–343S. doi: 10.1378/chest.102.1.38S
42.
Myers JL Colby TV . Pathologic manifestations of bronchiolitis, constrictive bronchiolitis, cryptogenic organizing pneumonia, and diffuse panbronchiolitis. Clin Chest Med. (1993) 14:611–2. doi: 10.1016/S0272-5231(21)00925-4
43.
Feinstein MB DeSouza SA Moreira AL Stover DE Heelan RT Iyriboz TA et al . A comparison of the pathological, clinical and radiographical, features of cryptogenic organising pneumonia, acute fibrinous and organising pneumonia and granulomatous organising pneumonia. J Clin Pathol. (2015) 68:441–7. doi: 10.1136/jclinpath-2014-202626
44.
Lappi-Blanco E Soini Y Paakko P . Apoptotic activity is increased in the newly formed fibromyxoid connective tissue in bronchiolitis obliterans organizing pneumonia. Lung. (1999) 177:367–6. doi: 10.1007/PL00007654
45.
Lappi-Blanco E Kaarteenaho-Wiik R Soini Y Risteli J Pääkkö P . Intraluminal fibromyxoid lesions in bronchiolitis obliterans organizing pneumonia are highly capillarized. Hum Pathol. (1999) 30:1192–6. doi: 10.1016/S0046-8177(99)90036-9
46.
Cai M Bonella F Dai H Sarria R Guzman J Costabel U . Macrolides inhibit cytokine production by alveolar macrophages in bronchiolitis obliterans organizing pneumonia. Immunobiology. (2013) 218:930–7. doi: 10.1016/j.imbio.2012.10.014
47.
Radzikowska E Roży A Jaguś P Wiatr E Gawryluk D Chorostowska-Wynimko J et al . Cryptogenic organizing pneumonia: IL-1β, IL-6, IL-8, and TGF- β1 serum concentrations and response to clarithromycin treatment. Adv Exp Med Biol. (2016) 911:77–85. doi: 10.1007/5584_2016_223
48.
Radzikowska E Roży A Jagus P Polubiec-Kownacka M Wiatr E Chorostowska-Wynimko J et al . Clarithromycin decreases IL-6 concentration in serum and BAL fluid in patients with cryptogenic organizing pneumonia. Clin Exp Med. (2016) 25:871–8. doi: 10.17219/acem/61953
49.
Katoh S Ikeda M Shimizu H Abe M Ohue Y Mouri K et al . Increased Galectin-9 concentration and number of CD4+Foxp3high+cells in bronchoalveolar lavage fluid of patients with cryptogenic organizing pneumonia. Lung. (2015) 193:683–9. doi: 10.1007/s00408-015-9775-x
50.
Todd NW Marciniak ET Sachdeva A Kligerman SJ Galvin JR Luzina IG et al . Organizing pneumonia/non-specific interstitial pneumonia overlap is associated with unfavorable lung disease progression. Respir Med. (2015) 109:1460–8. doi: 10.1016/j.rmed.2015.09.015
51.
Yang DG Kim KD Shin DH Choe KO Kim SK Lee WY . Idiopathic bronchiolitis obliterans with organizing pneumonia presenting with spontaneous hydropneumothorax and solitary pulmonary nodule. Respirology. (1999) 4:267–13. doi: 10.1046/j.1440-1843.1999.00187.x
52.
Kang C Vali Y Naeem M Reddy R . Cryptogenic organising pneumonia presenting with spontaneous pneumothorax and the value of procalcitonin: a case report. Respir Med Case Rep. (2017) 22:36–8. doi: 10.1016/j.rmcr.2017.06.006
53.
Meyer KC Raghu G Baughman RP Brown KK Costabel U du Bois RM et al . An official American Thoracic Society clinical practice guideline: the clinical utility of bronchoalveolar lavage cellular analysis in interstitial lung disease. Am J Respir Crit Care Med. (2012) 185:1004–14. doi: 10.1164/rccm.201202-0320ST
54.
Costabel U Teschler H Guzman J . Bronchiolitis obliterans organizing pneumonia (BOOP): the cytological and immunocytological profile of bronchoalveolar lavage. Eur Respir J. (1992) 5:791–7. doi: 10.1183/09031936.93.05070791
55.
Poletti V Cazzato S Minicuci N Zompatori M Burzi M Schiattone ML . The diagnostic value of bronchoalveolar lavage and transbronchial lung biopsy in cryptogenic organizing pneumonia. Eur Respir J. (1996) 9:2513–6. doi: 10.1183/09031936.96.09122513
56.
Ravaglia C Wells AU Tomassetti S Gurioli C Gurioli C Dubini A et al . Diagnostic yield and risk/benefit analysis of trans-bronchial lung cryobiopsy in diffuse parenchymal lung diseases: a large cohort of 699 patients. BMC Pulm Med. (2019) 19:16. doi: 10.1186/s12890-019-0780-3
57.
Roberton BJ Hansell DM . Organizing pneumonia: a kaleidoscope of concepts and morphologies. Eur Radiol. (2011) 21:2244–54. doi: 10.1007/s00330-011-2191-6
58.
Miao L Wang Y Li Y Ding J Chen L Dai J et al . Lesion with morphologic feature of organizing pneumonia (OP) in CT-guided lung biopsy samples for diagnosis of bronchiolitis obliterans organizing pneumonia (BOOP): a retrospective study of 134 cases in a single center. J Thorac Dis. (2014) 6:1251–60. doi: 10.3978/j.issn.2072-1439.2014.08.23
59.
Guerry-Force ML Müller NL Wright JL Wiggs B Coppin C Pare PD et al . A comparison of bronchiolitis obliterans with organizing pneumonia, usual interstitial pneumonia, and small airways disease. Am Rev Respir Dis. (1987) 135:705–2. PMID:
60.
Xaubet A Ancochea J Morell F Rodriguez-Arias JM Villena V Blanquer R et al . Spanish group on interstitial lung diseases, SEPAR. Report on the incidence of interstitial lung diseases in Spain. Sarcoidosis Vasc Diffuse Lung Dis. (2004) 21:64–70.
61.
Yousem SA Lohr RH Colby TV . Idiopathic bronchiolitis obliterans organizing pneumonia/cryptogenic organizing pneumonia with unfavorable outcome: pathologic predictors. Mod Pathol. (1997) 10:864–1. PMID:
62.
Lohr RH Boland BJ Douglas WW Dockrell DH Colby TV Swensen SJ et al . Organizing pneumonia. Features and prognosis of cryptogenic, secondary, and focal variants. Arch Intern Med. (1997) 157:1323–9. doi: 10.1001/archinte.1997.00440330057006
63.
Barroso E Hernandez L Gil J Garcia R Aranda I Romero S . Idiopathic organizing pneumonia: a relapsing disease. 19 years of experience in a hospital setting. Respiration. (2007) 74:624–1. doi: 10.1159/000103240
64.
Sveinsson OA Isaksson HJ Sigvaldason A Yngvason F Aspelund T Gudmundsson G . Clinical features in secondary and cryptogenic organising pneumonia. Int J Tuberc Lung Dis. (2007) 11:689–4. PMID:
65.
Nizami IY Kissner DG Visscher DW Dubaybo BA . Idiopathic bronchiolitis obliterans with organizing pneumonia an acute and life-threatening syndrome. Chest. (1995) 108:271–7. PMID:
66.
Saito Z Kaneko Y Hasegawa T Yoshida M Odashima K Horikiri T et al . Predictive factors for relapse of cryptogenic organizing pneumonia. BMC Pulm Med. (2019) 19:10. doi: 10.1186/s12890-018-0764-8
67.
Ichikawa Y Ninomiya H Katsuki M Hotta M Tanaka M Oizumi K . Low-dose/long-term erythromycin for treatment of bronchiolitis obliterans organizing pneumonia (BOOP). Kurume Med J. (1993) 40:65–7. doi: 10.2739/kurumemedj.40.65
68.
Radzikowska E Wiatr E Langfort R Bestry I Rudziński P Roszkowski K . Organizing pneumonia-own experiences with clarithromycin treatment. Pneumonol Alergol Pol. (2004) 72:493–8. doi: 10.5603/ARM.28186
69.
Stover DE Mangino D . Macrolides: a treatment alternative for bronchiolitis obliterans organizing pneumonia?Chest. (2005) 128:3611–7. doi: 10.1378/chest.128.5.3611
70.
Ding QL Lv D Wang BJ Zhang QL Yu YM Sun SF et al . Macrolide therapy in cryptogenic organizing pneumonia: a case report and literature review. Exp Ther Med. (2015) 9:829–4. doi: 10.3892/etm.2015.2183
71.
Pathak V Kuhn JM Durham C Funkhouser WK Henke DC . Macrolide use leads to clinical and radiological improvement in patients with cryptogenic organizing pneumonia. Ann Am Thorac Soc. (2014) 11:87–91. doi: 10.1513/AnnalsATS.201308-261CR
72.
Lee J Cha SI Park TI Park JY Jung TH Kim CH . Adjunctive effects of cyclosporine and macrolide in rapidly progressive cryptogenic organizing pneumonia with no prompt response to steroid. Intern Med. (2011) 50:475–9. doi: 10.2169/internalmedicine.50.4237
73.
Vieira AL Vale A Melo N Caetano Mota P Jesus JM Cunha R et al . Organizing pneumonia revisited: insights and uncertainties from a series of 67 patients. Sarcoidosis Vasc Diffuse Lung Dis. (2018) 35:129–8.
74.
Ciftci F Kumbasar ÖÖ . Seven patients with cryptogenic organizing pneumonia succesfully treated with clarithromycin. Sarcoidosis Vasc Diffuse Lung Dis. (2018) 35:165–13.
75.
Petitpierre N Cottin V Marchand-Adam S Hirschi S Rigaud D Court-Fortune I et al . A 12-week combination of clarithromycin and prednisone compared to a 24-week prednisone alone treatment in cryptogenic and radiation-induced organizing pneumonia. Sarcoidosis Vasc Diffuse Lung Dis. (2018) 35:230–8.
76.
Nishino M Mathai SK Schoenfeld D Digumarthy SR Kradin RL . Clinicopathologic features associated with relapse in cryptogenic organizing pneumonia. Hum Pathol. (2014) 45:342–1. doi: 10.1016/j.humpath.2013.09.010
77.
Gomes R Padrão E Dabó H Soares Pires F Mota P Melo N et al . Acute fibrinous and organizing pneumonia: a report of 13 cases in a tertiary university hospital. Medicine (Baltimore). (2016) 95:e4073. doi: 10.1097/MD.0000000000004073
78.
Dai JH Li H Shen W Miao LY Xiao YL Huang M et al . Clinical and radiological profile of acute fibrinous and organizing pneumonia: a retrospective study. Chin Med J. (2015) 128:2701–6. doi: 10.4103/0366-6999.167293
79.
Lu J Yin Q Zha Y Deng S Huang J Guo Z et al . Acute fibrinous and organizing pneumonia: two case reports and literature review. BMC Pulm Med. (2019) 19:141. doi: 10.1186/s12890-019-0861-3
80.
Xu XY Chen F Chen C Sun HM Zhao BL . Acute fibrinous and organizing pneumonia: a case report and literature review. Exp Ther Med. (2016) 12:3958–62. doi: 10.3892/etm.2016.3865
81.
Lee JH Yum HK Jamous F Santos C Campisi A Surani S et al . Diagnostic procedures and clinico-radiological findings of acute fibrinous and organizing pneumonia: a systematic review and pooled analysis. Eur Radiol. (2021) 31:7283–94. doi: 10.1007/s00330-021-07868-z
82.
Zaizen Y Tabata K Yamano Y Takei R Kataoka K Shiraki A et al . Cicatricial organising pneumonia associated with fibrosing interstitial pneumonia - a clinicopathological study. Histopathology. (2022) 80:279–13. doi: 10.1111/his.14427
83.
Woge MJ Ryu JH Bartholmai BJ Yi ES . Cicatricial organizing pneumonia: a clinicopathologic and radiologic study on a cohort diagnosed by surgical lung biopsy at a single institution. Hum Pathol. (2020) 101:58–63. doi: 10.1016/j.humpath.2020.04.013
Summary
Keywords
cryptogenic organizing pneumonia, secondary organizing pneumonia, acute fibrinous organizing pneumonia, cicatrices organizing pneumonia, prednisone, clarithromycin
Citation
Radzikowska E and Fijolek J (2023) Update on cryptogenic organizing pneumonia. Front. Med. 10:1146782. doi: 10.3389/fmed.2023.1146782
Received
17 January 2023
Accepted
03 April 2023
Published
20 April 2023
Volume
10 - 2023
Edited by
Shuibang Wang, National Institutes of Health (NIH), United States
Reviewed by
Nicol Bernardinello, University of Padua, Italy; Gaetano Rea, Monaldi Hospital, Italy
Updates
Copyright
© 2023 Elzbieta and Justyna.
This is an open-access article distributed under the terms of the Creative Commons Attribution License (CC BY). The use, distribution or reproduction in other forums is permitted, provided the original author(s) and the copyright owner(s) are credited and that the original publication in this journal is cited, in accordance with accepted academic practice. No use, distribution or reproduction is permitted which does not comply with these terms.
*Correspondence: Elzbieta Radzikowska, e.radzikowska@wp.pl
†ORCID: Elzbieta Radzikowska, https://orcid.org/0000-0002-2585-8594
Justyna Fijolek, https://orcid.org/0000-0002-9135-1580
Disclaimer
All claims expressed in this article are solely those of the authors and do not necessarily represent those of their affiliated organizations, or those of the publisher, the editors and the reviewers. Any product that may be evaluated in this article or claim that may be made by its manufacturer is not guaranteed or endorsed by the publisher.